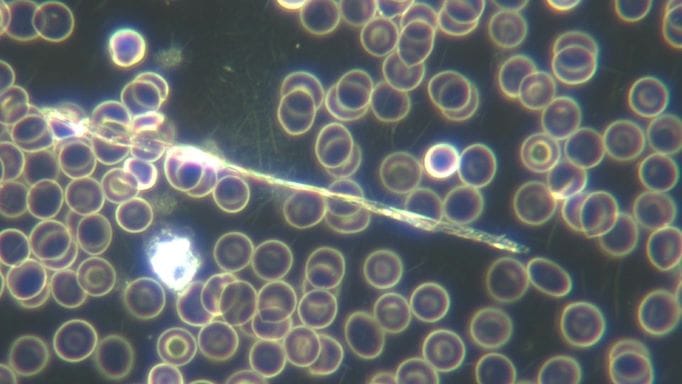

Table of Contents
New Zealand Doctors Speaking Out With Science
nzdsos.com
Information
Opinion
NZDSOS has been drawing attention to impurities in the vaccines, and the blood and bodies of the vaccinated, since September 2021 and subsequently, via numerous emails to officials, open letters and posts. Much of this is around microscope evidence, but which sits alongside the ‘macro’ signs of unexplained and shocking sudden deaths in younger people and rising all-cause mortality in all vaccinated age groups, as reflected in official government statistics from all around the world.
Funeral Directors Findings
This year an extra piece of the jigsaw has come from embalmers and funeral directors who are seeing booming business from the unprecedented deaths overall, but also claims of many more child and baby deaths, and the appearance of ‘strange fibrous structures’ in blood vessels of the dead that were never seen before the rollout. The linked video with outspoken funeral director John O’Looney in the UK has additonal links to other embalmers, notably Richard Hirschman from the US, who has also found these same bizarre structures.

Scientist Mike Adams has analysed these structures and proved they are not normal blood clots, but particularly concentrate highly conductive elements of tin, aluminium and sodium. These first 2 elements find their way in to the body through toxic and industrial activities, but they seem to get concentrated into these fibrous clots.
We believe that the microscopic tubular structures showing up in the blood of vaccinated people deserve serious examination – and immediate withdrawl of further injections while this is done – but only the willfully blinded or dumbest officials would dismiss a possible link to the bizarre structures being pulled from people’s blood vessels, which also deserve urgent assessment in their own right:
What are these structures doing in vaccinated blood?

New Zealand embalmer and funeral director Brenton Faithfull JP is doing the right thing and going public with his experiences too.
Watch: Funeral Directors Testimony
He must not be ignored. He kept a tally as client numbers started to increase following the rollout.
95% of his clients over the following 12 months were vaccinated within 2 weeks of their deaths.
Brenton makes a good point about death certificates recently moving online and no need for a doctor necessarily to see the body in person. He is one of a handful here in New Zealand who has raised eyebrows on what they have seen since the rollout, but there are another 800 businesses who may well have the same stories. Remember, they were all required to be jabbed to keep their businesses going, whatever their misgivings. How must they have felt if they saw many of their clients had died shortly following a jab, as Brenton has reported? One quipped darkly “It gives new meaning to the phrase ‘shot to death’ “.
We have been asking why coroners – in fact, ALL relevant officials, and the police – have ignored highly suspicious deaths, and why some families’ requests for post mortem examinations have been blocked.
We have written on the conflicts of interest that our high profile “celebrity” pathologist clearly demonstrates (can this person really be trusted to impartially investigate a possible vaccine death?), and talked to one pathologist, particularly who spoke of a culture of “hear no evil, see no evil” regarding jabs causing deaths.
All in all, we are despairing of the continued death and injury toll on our fellow citizens, but we cannot and will not stop following the facts.
Like this one. The government is proposing changes to the Coroner’s Act that creates a second-tier Coronial Associate, who has the power to declare a death of unknown cause to be due to “unascertained natural causes” nonetheless, and declare the case closed with no need for an inquest, inquiry or even a post mortem. The vapid excuse for these changes is to ‘free up’ Coroners to investigate and bring closure to more ‘complex cases’ in a more timely manner.
Well, not having even received the courtesy of an acknowledgement let alone a reply from the Chief Coroner to our information and questions on sudden adult and child deaths that are “baffling, befuddling and mysterious” to many doctors (not us), or to why Auckland coroner Deborah Marshall ruled out the vaccine impossibly quickly following the sudden death from blood clots of a 17-year-old girl, it might look to the casual observer to be a scurrilous attempt to sweep possible medical misadventure under the carpet and further insulate Pfizer from any scrutiny.
Literally, evidence might be buried, or incinerated, forever.
Almost the entire medical and legal professions, as well as parliament and public servants, will be tarred with this sweeping brush if this change is allowed to go through. People must make submissions so the lawmakers know that we know what they are enabling. They can be brief and to the point. We need more coroners, not less, so that SADS is not covered up. It is possible that the MPs hearing public submissions may be clueless on these matters, so we must all try to educate them. The link to submit is here: parliament.nz/en/pb/sc/make-a-submission/document/53SCJU_SCF_BILL_125886/coroners-amendment-bill
There was already a shortage of coroners (and autopsy pathologists ) before covid, and it is deeply unfortunate that only lawyers can become coroners, unlike the UK for instance where doctors can be appointed too. Since all NZ’s pathologists ( who do autopsies and other tests to determine cause of death) are doctors, they are beholden to the Medical Council’s stern and unquestioning promotion of the narrative, and know that “anti-vaccine sentiment will not be tolerated”.
Thus, there is a near perfect storm of lawyers-as-coroners who have no apparent idea of the frequency and nature of deaths in the community ‘in normal times’, and pathologists who are afraid to look and find. We have heard stories of police deviating from normal processes at the scene of sudden deaths, too.
We are aware that the current coronial process is already inadequate and that families and the community wait far too long for outcomes, but the solution is not an extra underlayer of less comprehensive service, rather it is to have a sufficient number of highly qualified coroners doing the full assessments required. The possibility of doctors being appointed to coronial positions should be considered.
Bhakdi and Burkhardt have shown that in 93% of cases medical examiners miss signs that a vaccine harmed the deceased. (This is one of many pieces of evidence summarised powerfully by prolific researcher Steve Kirsch here in what one can say is a ‘reference to end all references’, in a similar vein to the very early appearing nojabforme.info, which is continuously updated.) We too have accrued and presented solid piles of evidence to illustrate the picture of a terrible public health tragedy that far too many are still not awake to.
Even many of the thousands of bereaved Kiwis left dazed and confused at the suddenness of their loss, just “cannot go there”. Who knew, when voting for End of Life Choice as a majority did in 2020, that capital punishment would sneak through the back door? Uh? Death by lethal injection, of course.
Our collective psyche is extremely well understood by bad people, and it has been weaponised against us. High intelligence is no protection against manipulation. But wake up we must, or we could lose everything. If a few truly evil people can cause mass deaths and injuries for their own ends, stealing from us is surely a breeze.
As the world marches closer to a terrifying nuclear war (now there’s a tautology!), inevitable financial collapse, contrived food and energy shortages, and digital control of our money (and maybe of our very minds and bodies if the graphene additions to the injections are added to that end) who can really blame any of us for running and hiding? However, coroners have always served as public sentinels, on the lookout for plague, poisoning or foul play as shown up in patterns of death, so the community is warned and can take action. Until now, that is. Please, submit on this crucial issue or one more previously protective barrier to wrongdoing will bite the dust.